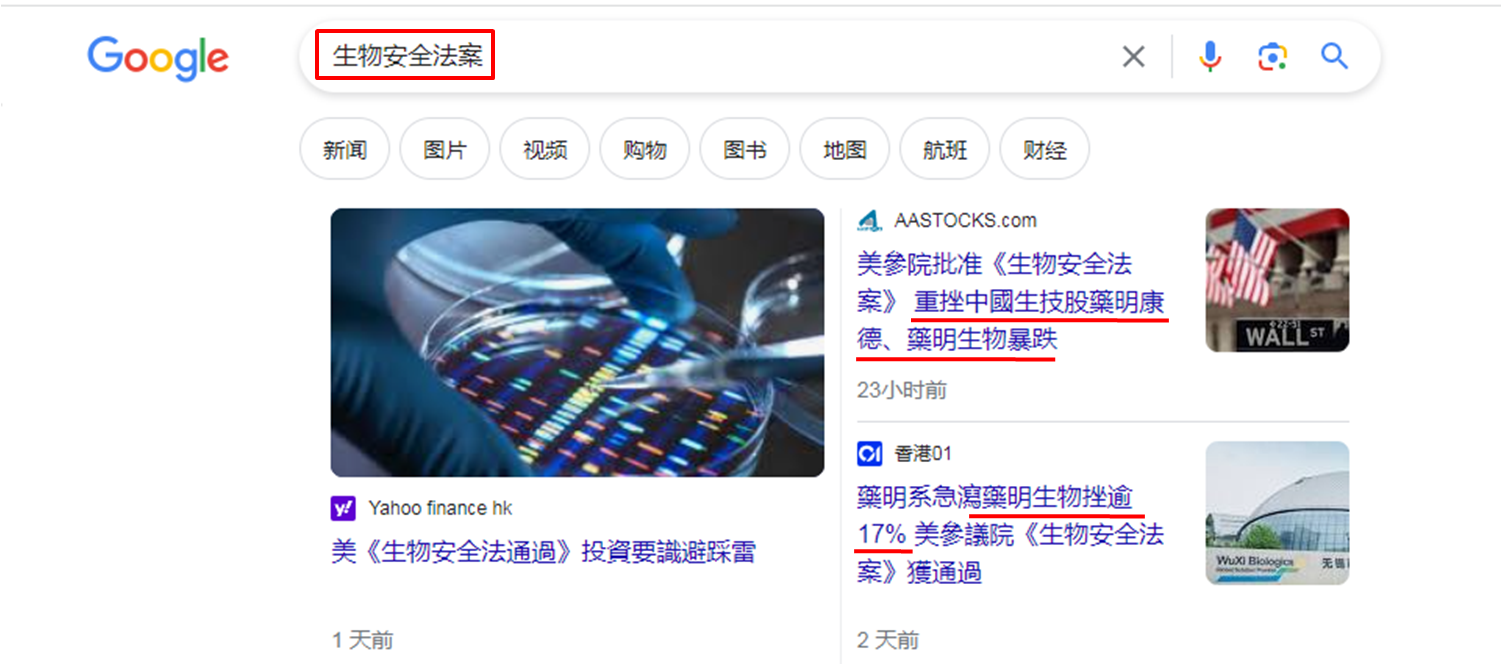

上周二 (3月6日) 国家总理发表任内首份「政府工作报告」,宣布今年内地经济增长目标为5%左右 (与去年目标相同) 后,市场暂对目标能否达成持观望态度,令港股缺乏方向。周二至周五恒指日跌日升,介乎16,095至16,545点之间,仅约450点窄幅上落。笔者留意周三至周五分别高见16,545、16,512和16,489点,于16,500点之上渐见下移,并于过去四个交易日均收低于16,500点,现需留意此水平或已形成阻力。即或本周能收高于16,500点,后市依然未许乐观,皆因港股价与量均暂未反映具上扬条件。
内房股见国策利好消息
就「价」而言,自去年8月8日至今超过七个月,除了今年2月27日,其余日子均收低于100天移动平均线,明显要见充裕动力才能突破并企稳在此线之上。于上周四发布市评文章,在文末表示从增长目标为5%左右来看,市场认为因着去年的GDP高基数,短期内会有积极推动经济国策及措施出台;于此前提下未来一周憧憬企稳100天移动平均线之上。但于上周三至周五均未见相关利好消息,只见全国政协经济委员会建立房地产预售资金保障机制,预期有一万亿元人民币的资金,可由内房企业立即使用。

数据源:阿思达克财经网
留意十天线或成阻力位
消息刺激上周五内房股普遍上扬,恒指亦稍见提振,最多升近260点,最终升幅收窄至123点,收报16,353点,低于3月5日低位16,473点,处于回补3月4及5日之间出现的下跌裂口状态。此外,过去四个交易日均收低于10天线,恒指于2月14日至3月4日历时接近三周,除了2月29日,均收高于此线,理应是较强支持位,如今此线多日失守,留意本周于100天线以外,是否10天线亦成阻力位。至于就「量」而言,于2月29日大市成交金额录得约1,304亿港元,为1月29日以来最高,之后渐见减少,呈现「价平量缩」。
美国通过生物安全法案
上周四和周五分别约980亿和867亿元,同见少于1,000亿元,回到农历新年假期前水平。于今年1月29日大市成交额约1,001亿元,当日恒指收报16,077点,较现于16,353点低近280点。倘若今年1月底港股价量均在合理水平,即大市成交额约1,000亿元,恒指便处于16,000点水平。如今成交额不足870亿元,恒指合理位置应在16,000点以下。另可留意消息面也见利淡因素,美国参议院针对中国生科企业的《生物安全法案》于美国时间3月6日获通过,故此3月7日药明系、医药及生科股的价格急挫。
数据源:谷歌搜寻器
之后又有美国议员敦促政府提高中国电动车进口关税应对国安风险,以及外媒报导指美国政府敦促荷兰阻止当地芯片设备公司ASML,为中国客户保养,以及维修芯片生产设备。美国亦希望日本限制对华出口生产芯片必需用到的化学材料光刻胶。同一时间,美国政府试图拉拢德国、南韩加入对华的芯片业限制。故此在港上市的医药及生科股之外,电动车股和大型科技股同见短期较高捱沽风险。考虑到消息面偏负,恒指与100天线的互动,从憧憬企稳其上转为继续受制,主要波幅区间为16,100至16,600点。
聂振邦(聂Sir)
笔者确认本人及其有联系者均没有出现以下两种情况,其一是在执笔前三十天内曾交易上述分析股票;其二在文章发出后三个营业日内交易上述的股票。此外,笔者现时也并未持有上述股份。
以上纯属个人研究分享,并不代表任何第三方机构立场,亦非任何投资建议或劝诱。读者务请运用个人独立思考能力自行作出投资决定。